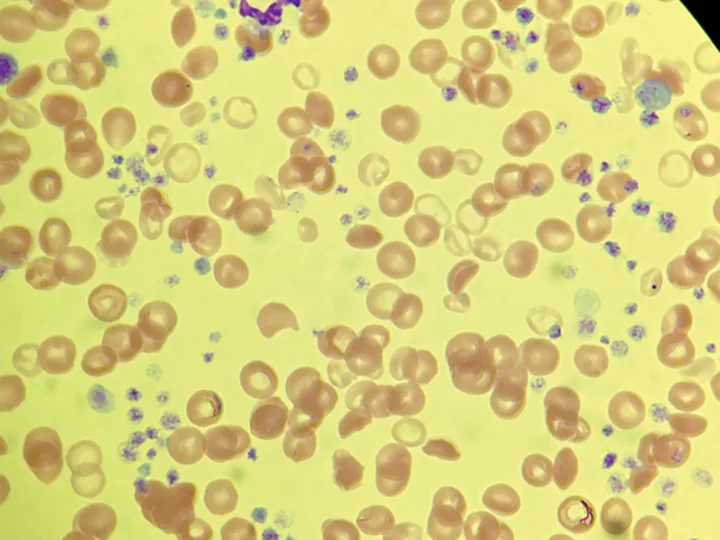

Primary Immune-Mediated Thrombocytopenia in Dogs
Marie Chartier, DVM, DACVIM, VCA Roberts Animal Hospital, Hanover, Massachusetts

Profile
Definition
Thrombocytopenia is a deficiency of platelets in the blood.
Four main pathogenic mechanisms can cause thrombocytopenia:
Decreased platelet production
Platelet destruction
Platelet consumption
Abnormal platelet distribution/sequestration
In immune-mediated thrombocytopenia (IMT), the deficiency is caused by immune-mediated destruction of platelets.
Platelets aid in forming blood clots.
Signalment
The incidence of primary IMT is high in middle-aged female dogs, cocker spaniels, Old English sheepdogs, German shepherd dogs, and poodles.1,2
Causes
IMT can be primary or secondary.
Primary IMT is an autoimmune disorder with production of antibodies directed against normal platelet antigens.
Secondary IMT occurs in association with infection, drug therapy, neoplasia, poly-immune syndromes, or complication of platelet transfusion.1
Vaccination as a cause of secondary IMT is possible.3
Pathophysiology
IMT occurs when an animal’s immune system produces antibodies that bind directly or indirectly to its own platelets; this leads to accelerated platelet destruction by the mononuclear phagocyte system.4,5
Primary IMT is usually mediated by immunoglobulin G directed against platelet membrane glycoprotein IIb/IIIa.1
Secondary IMT occurs when antibodies target nonself antigens adsorbed onto the surface of platelets or when immune complexes become bound to platelet surfaces.6
History & Clinical Signs
Travel, vaccination, medication, and tick prevention history are important in cases of thrombocytopenia to rule out causes of secondary IMT.
Patients with IMT are often subclinically affected or are presented with clinical signs attributed to bleeding.
The GI tract can be a site of hemorrhage in these patients.
Intracavitary bleeding is uncommon.
Systemic clinical signs are often seen only if a secondary anemia is present.
Some dogs without anemia will be presented for nonspecific clinical signs such as lethargy or anorexia.
Physical Examination
Findings can include epistaxis, gingival bleeding, petechiae and ecchymoses (Figure 1), bruising, hematochezia, melena, and hematuria.
An ophthalmologic examination is recommended to look for changes such as hyphema, anterior uveitis, and retinal hemorrhage.
Clinical signs of anemia may be present.
This can include pale pink mucous membranes, weakness, tachycardia, bounding pulse, heart murmur, and tachypnea.

Figure 1. Ecchymoses on the ventral abdomen of a patient with IMT.
Diagnosis
Definitive
Diagnosis of thrombocytopenia is by manual platelet count.
In order to diagnose primary IMT, all non-immunologic and secondary causes of IMT must be ruled out.
Diagnosis is confirmed when response to immunosuppressive therapy is observed.
Differentials
Decreased platelet production: drugs, infection, irradiation, myelonecrosis, myelofibrosis, neoplasia4
Platelet destruction: idiopathic, drugs, infection (tick-borne disease), neoplasia, platelet transfusion, systemic immune-mediated disease (systemic lupus erythematosus)4
Platelet consumption: blood loss, disseminated intravascular coagulation, endotoxemia, vasculitis4
Abnormal platelet distribution or sequestration: splenomegaly, endotoxemia4
Laboratory Findings
Serum chemistry panel and coagulation profiles are often normal in cases of primary IMT.
Hematuria may be evident on urinalysis.
Cystocentesis should be avoided in patients with thrombocytopenia.
CBC can give an automated platelet count.
The normal canine platelet count is 143 to 448 × 103/µL.
If platelet clumping is present, a false thrombocytopenia may occur.
All cell lines (WBCs, RBCs, platelets) should be evaluated.
Decreases in multiple cell lines can be associated with decreased cell production because of disease at the bone marrow level.
A CBC with reticulocyte count should be performed to look for anemia secondary to blood loss from IMT or concurrent immune-mediated hemolytic anemia.
Manual platelet count
The feathered edge and blood smear body should be scanned for an area of well-distributed platelets (Figure 2).
The number of platelets per 1000× field should be estimated.
At least 5 to 10 fields should be evaluated and the average number of platelets/hpf calculated.4
The conversion factor of 1 platelet/1000× field equals 20 000 platelets/μL can be used to calculate the platelet count.4
Platelet counts in cases of IMT are usually <50 000/μL and often <10 000/μL.
Megakaryocytes may be present.4,5
With a mean platelet count of approximately 150 000/μL, healthy greyhounds can have lower platelet concentrations than other breeds.1,4
Healthy Cavalier King Charles spaniels can have a hereditary macrothrombocytopenia, with the platelet count in affected dogs ranging from 25 000 to 100 000/μL.1
Figure 2. Blood smear of a canine patient with a normal platelet count (10× magnification).
Imaging
Thoracic radiographs are recommended to evaluate for thoracic infection or neoplasia.
These are usually normal in animals with primary IMT.
Abdominal ultrasonography can evaluate for the presence of abdominal bleeding, infection, or neoplasia.
Homogenous splenomegaly can be seen with primary IMT, especially if secondary anemia is present.
If diffuse splenic mottling is present, fine-needle aspiration may be recommended once the platelet count is adequate.
Infectious Disease Testing
Ehrlichiosis, Rocky Mountain spotted fever, anaplasmosis, histoplasmosis, leishmaniasis, and distemper have been associated with secondary IMT.4
Tick-borne disease testing is recommended; complete panels include both polymerase chain reaction (PCR) and serology.
PCR is often positive early in active disease.
Negative PCR results do not rule out infection, and a positive serologic test does not necessarily confirm disease.
Serology is often positive after PCR because it takes time for antibodies to be produced.
Advanced Testing
The benefit of bone marrow examination in cases of suspected IMT is equivocal.
Normal-to-increased numbers of bone marrow megakaryocytes may not be a consistent finding.2
Flow cytometric assays to detect antiplatelet antibodies are available but are not commonly performed in the clinical setting.
A positive test implicates an immune pathogenesis but is not specific for primary IMT.
False-negative results are possible, especially if therapy was started before testing.2,5
Treatment
Emergency Treatment
Many IMT patients can be treated on an outpatient basis, but it is important for owners to monitor for signs of bleeding or anemia and to avoid trauma or injury.
Patients are often hospitalized initially for monitoring or if they require a blood transfusion because of secondary anemia.
Although uncommon, fatal bleeding into the brain, lungs, or spinal cord is possible.
Bleeding risk increases as platelet count decreases below 20 000/μL, although spontaneous bleeding typically does not occur, even with marked thrombocytopenia.
Platelet transfusions are usually reserved for cases of uncontrollable or life-threatening bleeding.
Blood or platelet transfusions do not significantly raise the platelet count but can be used in an attempt to stop life-threatening bleeding.
Vincristine (0.5–0.7 mg/m2 IV once) may have some immunosuppressant activity and may induce thrombocytosis within 7 days.
A peripheral catheter should be used for administration as extravasation of vincristine can cause skin necrosis.
Long-Term Treatment Options
Immunosuppressive agents
Prednisone (1–2.2 mg/kg q12h) is the initial immunosuppressive therapy of choice for dogs with IMT; the majority of dogs will show a significantly increased platelet count within 7 days.2,7,8
Additional immunosuppressive medications are usually needed only if significant prednisone side effects are present.
Azathioprine (2 mg/kg q24h, tapered to q48h after 1 week) has been described as an immunosuppressive option, but studies are lacking.
This medication can take more than 4 weeks to become effective.2,7,8
Cyclosporine (5–10 mg/kg divided q12h) has been shown to be an effective immunosuppressive medication in dogs with IMT.2,8
Mycophenolate mofetil (10 mg/kg PO q12h) has been reported to have variable response rates as an immunosuppressive medication for canine IMT in small studies.8
This drug can be considered in refractory cases.
Leflunomide has shown efficacy in anecdotal reports, but studies on this immunosuppressive medication for IMT are limited.6
Melatonin (3 mg PO q12h) has been suggested anecdotally (based on clinical response in humans) to increase platelet counts in cases of IMT.9
Human IV immunoglobulin (0.28–1.5 g/kg IV) has been shown to significantly reduce platelet recovery time and hospitalization when combined with prednisone given slowly over 4 to 12 hours.7,10,11
Human IVIG should be used with caution in patients with renal dysfunction.
Patients should be monitored for volume overload and hypersensitivity reactions.
Splenectomy has shown variable response rates but can be considered in refractory cases.2,8
Follow-Up
Immunosuppressive medications are tapered slowly once the platelet count has normalized.
Prednisone is usually tapered first as many dogs will have significant side effects from this medication.
If a second immunosuppressive medication is given, it is routinely tapered after the prednisone.
Medication is generally reduced by about 25% every 3 to 4 weeks.
Medications are usually tapered 1 medication at a time if multiple medications are given.
The minimum duration of treatment is usually 4 to 6 months.
The most common reason for treatment failure is an inadequate duration of therapy.
Patients should be evaluated via a manual platelet count 1, 3, and 6 months after treatment has been discontinued and then every 6 to 12 months for life to monitor for disease relapse.
A manual platelet count is usually performed before each medication adjustment.
In General
Relative Cost
$$$$–$$$$$
Prognosis
The prognosis for patients with primary IMT can be good with reported long-term mortality rates of 10% to 15%.2,5
Relapse has been reported in 9% to 40% of cases.2,5,8
Poor prognostic indicators may include melena or a high blood urea nitrogen concentration.12
IMT = immune-mediated thrombocytopenia, PCR = polymerase chain reaction
Editor's note: This article was originally published in September 2015 as "Canine Primary (Idiopathic) Immune-Mediated Thrombocytopenia"